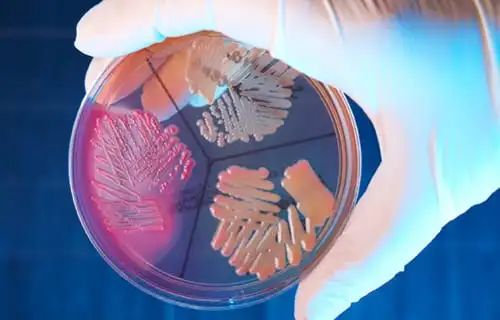

- +1
人体交易,长生不老的承诺?
原创 斯科特·卡尼 非虚构时间
无论是救死扶伤的器官移植,还是伤天害理的人口买卖,都建立在将人体作为商品的基础上。人类的生存、生活需要大量人体原材料,理解了这一点,也就不会轻易谈“人体交易”色变了。
《人体交易》
(美)斯科特·卡尼 著,姚怡平 译
毋庸讳言,人体在现今社会就是一种带有人性特征、具有市场价值但又会引发不安的商品。比如,人用疫苗需要以人体实验为基础,人类卵子可以制造胚胎干细胞。胚胎干细胞被医学界称为“万用细胞”,具有自我复制能力,可以再生人体各种组织器官。随着年龄增长,人体内干细胞的数量逐渐减少,功能逐渐衰减,造成人体不断衰老。胚胎干细胞和再生医学研究,不啻为对人类许下长生不老的承诺。

 人体交易和长生不老的承诺
人体交易和长生不老的承诺文 | [美]斯科特·卡尼
译 | 姚怡平
摘自《人体交易》
内容经过编辑,小标题为编辑所加
在塞浦路斯的一家生育诊所里,英俊潇洒的胚胎学家萨瓦斯·考道洛斯现在从事的是人类卵子生意,但是生殖生意的业务不光是制造婴儿。“在这里,最有故事的是干细胞。不久之后,我就会开发出一种新的方法制造胚胎干细胞,不用卵子就能办到。”
新材料的缺乏是临床进展的一大阻碍。直到2009年,奥巴马总统才终于撤销了禁令。不过这数十年来,胚胎干细胞研究一直是颇受争议的战场,有远见的科学家认为干细胞是极为有益的医学分支的基石,宗教团体则因为目前的胚胎研究会杀死潜在人类生命而提出反对。
然而考道洛斯说,他的实验室以后将可以避开宗教人士的抗议,根本不用破坏卵子,而是从骨髓或皮肤组织中培养干细胞。或许在这样的医学进步之下,实验室就能够再生整个器官、修复受损的组织,还有可能让人永远不死。
 科学家利用皮肤细胞建立了一个早期人类胚胎模型(照片:PA)
科学家利用皮肤细胞建立了一个早期人类胚胎模型(照片:PA)长生不老会是医学的再次飞跃吗?
全世界首次听说干细胞是在1963年,恩内斯特·阿姆斯特朗·麦卡洛克与詹姆斯·提尔这两位细胞科学家当时向大家证明了干细胞可转化成体内其他任何一种细胞。这类多能干细胞有可能是修复或替换受损人体组织的关键所在。到现在,我们已经耐心等待了超过一代人的时间,希望终有一日人体可被视为可再生资源。
我们现今会如此相信科学可以带来灵丹妙药,可能始于1928年苏格兰药理学家亚历山大·弗莱明无意间发现了盘尼西林,这是现代医学的第一个大变革。不到几年的时间,医院病房就能够抵御那些在术后造成患者死亡的感染,腺鼠疫几乎完全被根除,链球菌性咽喉炎、结核病、梅毒再也无法置人于死地。
 1928年,苏格兰药理学家亚历山大·弗莱明发现盘尼西林
1928年,苏格兰药理学家亚历山大·弗莱明发现盘尼西林抗生素的发现,加上安全的输血、公共卫生的改善、可降低婴儿死亡率的医院照护,使得发达国家的预期寿命增加了将近30岁之多。用著名科普作家乔纳森·韦纳的话说:
人类在20世纪期间所增加的……寿命,相当于人类在整个生存斗争中所增加的寿命。
韦纳在书中提到了一位鼓吹永生的未来学家奥布里·德格雷,此人笃信再生医学可以让人类寿命再飞跃一次,进而达到永生。他将死亡视为一种有待解决的疾病,当医学进步到所有疾病皆可治疗的程度时,死亡就只会是没保险的人会遇到的问题。
虽然德格雷及其追随者是科学界的异类,不过,相信医学可治疗病痛,也是人性使然。
 未来学家奥布里·德格雷
未来学家奥布里·德格雷某些时候,光是小小的进展就会让人觉得快要跨出惊人的一大步了。复杂器官的人工版本已经酝酿了50多年,终于在1946年发明了现在称为小透析机的第一颗人工肾脏。生物疗法的进展也加快了。在生物反应器和适应力强的细胞系的协助下,就有可能在实验室里培养人类皮肤供移植用。
有个问题是摆脱不了的:“要是医学已进入停滞期,该怎么办?”20世纪,抗生素似乎解决了感染问题,然而在过去30年间,耐药菌株却已经进化到可以让多数老的一线疗法失效。由抗生素免疫细菌引起的葡萄球菌感染,在短时间内就成为医院里的头号杀手。基因疗法也自从一名患者在临床试验期间死亡后走进了死胡同。除极少数的特例外,经FDA核准的干细胞疗法仍旧非常遥不可及。
via:rtmagazine.com
via:rtmagazine.com此外,目前没有药丸可以治疗癌症。艾滋病患者需服用大量使人衰弱的药物,才能将其维持在一种慢性病的状态。万络(Vioxx)增加了心脏病发作机率,不得不召回。百忧解有可能造成患者自杀,而且减轻抑郁的效用有时还不及普通的安慰剂。每年,FDA都会宣布召回了数百种经核准的药物与器械。
外科技术与医学成像方面每隔几年就会出现革命性的变化。在20世纪,对不同身体系统的切割、缝补和重建手法,堪称一次量子级的飞跃。而回顾19世纪第一个十年,动手术就等于判死刑。如今,肾脏移植手术也只需要几小时,髋关节置换手术已是家常便饭,我们活在手术室的黄金时代。
 via:photonshouse.com
via:photonshouse.com反观新药研发和再生医学却处于停滞状态,患者却是一刻也等不了。这样的差异使得世界各地的人体市场对人体组织的需求永无止境。人类学家凯瑟琳·沃尔德比写道,人体组织的市场存在,说明了“不可能通过理性的市场力量来管制人们对于躯体再生的幻想,因为这种幻想与人们对于驾驭时间的渴望,以及对于死亡的恐惧是联系在一起的”。
医疗行业让人们太容易把“有购买力”误认为“有免死权”。相比接受可能发生的死亡、让亲人准备好面对患者的死亡,倒不如选择合法或非法的市场,至少那里还贩卖续命的希望。
目前支配世界各地人体市场的道德观是假设可以在利他捐赠之上,以一种合乎道德的方式建立商业化的人体部位交易体系。然而,无偿捐赠器官的供应量相当不足,犯罪分子就会寻求非法手段来增加供应量。
 图源新加坡《联合早报》
图源新加坡《联合早报》要解决这种伪善,一种方法就是立法全面禁止用金钱交换人体组织与人体。当然,这也有可能反而让黑市更兴盛。另一种方法就是摒弃人类生来平等的观念,承认人体是商品,跟其他物品没什么两样;并且承认人体可以被当成零件对待,有些人永远是供应人体部位的一方,有些人永远是消费的一方。然而,大众不想接受开放的人体组织贸易,也不想要减少自己获得延命治疗的机会。换句话说,就是鱼与熊掌想兼得。
再生药物与人体市场
对于想要走在医学尖端、打破规定的医生而言,塞浦路斯岛有如安全的避风港。比如,当地的帕那伊欧提司·麦可·札瓦司医生宣布,他要不顾法律,成为第一位成功克隆人类的医生,并开始在自己的实验室里进行研发工作。
在石黑一雄的《莫失莫忘》一书中,克隆人的培养是为了捐器官给人类使用,而在科幻小说领域之外,就算克隆了人类,也无法阻挡市场对人体的无尽需求。然而,世界各地的研究人员正在寻找突破点,希望能稳定供应人造(且去除个人身份)的人体组织。如果成功了,那么就会完全改变人体交易的世界。
 电影《别让我走》剧照
电影《别让我走》剧照如果可以制造出产业级且生物学上完美的人造组织与器官,那么就再也没有理由经营血液农场或窃取肾脏了。如果注射干细胞就会长出新骨头,那么就再也没有人需要移植骨头了。而器官移植界的人会苦着脸说,再生医学会是未来趋势。考虑到今日人体市场的复杂度,若要瓦解当前的人体部位市场、消灭人体部位摘取网络,再生药物或许是唯一明智的方法。
第一个——有人说是最成功的——人造组织破坏人体组织市场的案例发生于1985年,当时生物技术巨头基因泰克公司使用重组的mRNA合成了人类生长激素(HGH)。在那之前,注射人类生长激素已证实可攻克幼童身上某些类型的侏儒症。然而,当时要取得人类生长激素,唯一的方法就是摘取尸体的脑垂体,挤出汁液,提取激素。但这需要大量的脑垂体才能制成一剂,供应来源也不稳定。1960年代至1980年代中期,美国的殡葬业者以及替警察部门进行尸检的病理学医生,摘取了数十万个脑垂体卖给制药公司,制药公司再处理成可注射的药剂。这是当时的标准做法,多数人终其一生并不知道自己所爱的人被切开卖掉。
 电影《别让我走》剧照
电影《别让我走》剧照人工制品甫一上市,脑垂体的交易便在一夜之间消失无踪。虽然人工合成生长激素的制造过程并不简单,也没有特别便宜,但是在人体部位市场,生长激素的供应链已经被连根拔起。
人工制品为各种人体市场带来了新希望。今日,有数十家——甚至数百家——小公司投资于再生研究,总有一天会有回报。一般而言,这类公司可划分成两个壁垒分明的阵营。一方是利用各种方式刺激人体自我疗愈能力的实验室,刺激的方式是提供可治疗受损或老化部位的细胞原料,或找出隐藏的遗传密码,活化蛰伏的疗愈性质。其中研究人员认为,人体懂得治疗自身的问题,只不过是需要一点协助才能完成工作。另一方往往对于自我再生的主题采取不可知论的态度,不过也假设只要有了足够的资料,就能够用技术知识来修正身体上的任何问题。用于置换的人体可以从头开始制作,然后通过外科手术来发挥作用。
这两派都有了初步的进展,并点燃了数百万患者的一线希望。然而,两方的研究展望实在太脱离现实了,不太可能在短时间内截断市场上对人体组织的需求。
 卡拉·阿鲁穆甘露出腹部的一条长疤痕,外科医生就是从这里摘取肾脏。虽然她在这张照片拍摄前几个月就动了手术,但是她仍然难以工作。她卖肾赚了一千美元。(图源:《人体交易》)
卡拉·阿鲁穆甘露出腹部的一条长疤痕,外科医生就是从这里摘取肾脏。虽然她在这张照片拍摄前几个月就动了手术,但是她仍然难以工作。她卖肾赚了一千美元。(图源:《人体交易》)不可复制的干细胞痊愈奇迹
2006年,在金奈某间通风良好的病房里,70岁的糖尿病患者瓦茉·卡塔夏斜倚在病床上。她说,要是没有医生的帮助,自己肯定再也不能走路了,这年早些时候,她注意到腿上有一个大小如针孔般的伤口,还以为会自愈。没想到几个星期稍没留意,伤口就扩散成溃疡,从脚跟到小腿肚,整整22英寸长。
像这样的腿部溃疡在糖尿病患者身上很常见。据美国糖尿病协会称,美国医院的非创伤性截肢当中,有近六成是溃疡(如卡塔夏腿上的溃疡)引起的,每年大约有8.2万例。虽然印度没有官方统计的截肢数据,但是印度次大陆的糖尿病发病率高过美国。
然而,卡塔夏不愿截肢。她跑遍南印度寻访可以提供其他选择的医生。最后,她找到了苏伯拉玛尼扬医生,这位医生前一阵子跟日本某家干细胞公司合作,打算试验新的再生疗法。卡塔夏除了腿上敞开的大伤口外,身体状况非常好,因此是进行试验的理想候选人。
计划看似简单。苏伯拉玛尼扬从卡塔夏的髋部抽取富含成人干细胞的骨髓,然后用离心机从普通血液细胞中分离出干细胞。在接下来的一周,他将干细胞制成溶液,注射到她的腿部,并移植了一片皮肤,覆盖在伤口上。
不到60天,溃疡已明显愈合,从治疗后所拍摄的血管造影照片中,可看到鲜明的亮白色动脉条痕。而在注射之前,她的腿几乎没有血液循环可言。干细胞显然已经重建了她大部分已萎缩的循环系统。
 这是瓦茉·卡塔夏的血管造影照片,影像显示了她在印度金奈接受实验性干细胞疗法后的腿部已长出静脉,亮白色的条痕就是新的血管。要是疗法没有成功的话,医师就必须切除她的腿。此后,这种成功案例再未出现。
这是瓦茉·卡塔夏的血管造影照片,影像显示了她在印度金奈接受实验性干细胞疗法后的腿部已长出静脉,亮白色的条痕就是新的血管。要是疗法没有成功的话,医师就必须切除她的腿。此后,这种成功案例再未出现。血管造影照片显示出她接受实验性干细胞疗法后的腿部已长出静脉,亮白色的条痕就是新的血管。不过,这种成功案例此后再未出现。
苏伯拉玛尼扬医生叫来了媒体,不久当地报纸开始颂扬这家不走寻常路的医学中心。不过,苏伯拉玛尼扬却解释说:“没人清楚背后的原理,不知怎的,干细胞一注射到体内后,就懂得如何转换成合适的细胞。”
对卡塔夏而言,痛苦已经消失了,不过,单一的成功案例称不上是干细胞疗法的革命。
“这是单一案例,而且没有对照组,”斯坦福大学外科副教授兼糖尿病护理专家杰弗瑞·葛纳表示,“我们都知道,在任何的疾病状态下,有些患者即使没有护理也能够复原,其背后的原因是我们无法完全了解的。”
坐飞机从金奈以北到新德里只需三小时,那里有一位姬塔·施洛夫医生,她对患者进行实验性的干细胞治疗,在该领域中堪称先驱人物。她不太想要了解干细胞确切的运作机制,只想要试用新方法,然后希望出现良好的成效。对于那些踏遍各地、试尽各种疗法却毫不见效的患者而言,最后能找的医生就只有她了。实验室里的她,热情地将自己的胚胎干细胞溶液注射到那些接二连三从世界各地前来的患者身上,借以治疗脊髓受损、进行性神经系统疾病以及绝症,每次的治疗费用为2万至3万美元不等。
 西方国家的科学家因为受到监管机构的辖制,很少会未先经过数年动物试验与毒性测试,就急于利用实验性干细胞鸡尾酒疗法来治疗患者。不过,印度并没有法律监管,这使得施洛夫的研究方案拥有了少许的自由度。可是,她不愿意让许多人进去看她的实验室,对于失败率也未曾透露过只字片语。
西方国家的科学家因为受到监管机构的辖制,很少会未先经过数年动物试验与毒性测试,就急于利用实验性干细胞鸡尾酒疗法来治疗患者。不过,印度并没有法律监管,这使得施洛夫的研究方案拥有了少许的自由度。可是,她不愿意让许多人进去看她的实验室,对于失败率也未曾透露过只字片语。当然,风险很大。如果任由干细胞在患者的血流里流窜,不去管它,只会有两种后果:一是发挥治疗功效并解决问题,二是任意转变成其他的细胞结构。最严重的一种状况就是转变成畸胎瘤,畸胎瘤是一种会随意突变的肿瘤,最大的特点在于肿瘤内部有时会带有些许的头发和牙齿,若畸胎瘤长在体内不适当的地方,有可能会致命。
如果不清楚干细胞的运作方式,也不清楚干细胞在哪些情况下会转变成有用的构造,或是哪些情况下会不受控制地扩散,那么在人体上试验确实有很大的风险。每一次注射施洛夫的鸡尾酒,有可能就是在玩俄罗斯轮盘赌,其结果就如在不知道有不同血型的情况下接受输血,有时置人死地,有时救人一命。
无法预测干细胞的去向,会造成很大的风险,在圣地亚哥便有一家公司为了降低风险,而把干细胞分别放到支架上,借以精确控制干细胞在人体内的去向。该公司认为这样就有可能搜集到足够的人类生理学数据,以期能够从头开始制造出替代的人体部位。
 3D打印人体器官?
3D打印人体器官?一家名为Organovo的小型生物科技公司,正在使用3D打印机制作替代器官与组织,日后将通过手术植入患者体内。该公司首席执行官基斯·墨菲毕业于麻省理工学院,还获得了商业学位。在他看来这个行业里的大多数干细胞疗法都落后了。2007年,Organovo的一个合作伙伴证实了跳动的心脏细胞排成一列时,就会以一致的节奏跳动。这项发现证明了在人工环境下,邻近的细胞可相互交流,而要打印出跳动的人工心脏,人工环境正是必备的先决条件。
不过,就目前而言,器官打印产业只是踏出了一小步。
 加州的生物创新公司实验室里的3D打印机。它用干细胞制成的墨水,打印出人体组织。有一天,有可能制造出人工器官,阻止非法人体组织市场的扩散。然而,这项技术仍面临多项重大挑战,有待克服。
加州的生物创新公司实验室里的3D打印机。它用干细胞制成的墨水,打印出人体组织。有一天,有可能制造出人工器官,阻止非法人体组织市场的扩散。然而,这项技术仍面临多项重大挑战,有待克服。加州的生物创新公司实验室里的3D打印机。它用干细胞制成的墨水,打印出人体组织。有一天,有可能制造出人工器官,阻止非法人体组织市场的扩散。
墨菲要我穿手术服,戴鞋套、口罩、工作帽,领我进入了无菌室。三名技术人员挤在一个长形的金属装置旁,该装置在细胞培养基上方来回移动一只梭子,动作有如喷墨打印机。事实上,这正是一种可以把细胞铺在模子里的3D打印机,最后可建构出替代的静脉和动脉。我造访的那天,打印机旁的冰箱里,两个卡尺之间悬着一条白色细丝,粗细略宽于一条天使意面。小小的组织还在成长中,不过,几天后,细胞就会从列印期间铺设的支架上长出来,然后彼此紧密结合。最后,它将能够承受相当于人类血压的压力,准备好进行移植。
设计器官打印机的人看待人体的角度,就有如泥瓦匠看待砖屋一样。人类有机体十分复杂又相互关联,不过终归是一堆细胞堆叠而成。如果有够详尽的图解指出各细胞的位置和类型,那么精密的机器就能视需要打印出人类零件。
 来源: 中科西部细胞研究院
来源: 中科西部细胞研究院这些过程的一开始是要先从预期的接受者身上取得细胞物质进行培养,这多半是指骨髓提取,或者是取得肝脏组织切片。然后,这些细胞会在实验室里成长,长到有足够的体量,就可以塑造成如油墨块般且可供打印的细胞。接着,打印机会沿着预设的图样,把每一个细胞放置在正确的位置上,建构出组织与器官。2010年,Organovo公司开始进行神经细胞与动脉的动物试验,期望在不久的将来能够进行人体试验。
器官打印术似乎有若干明显优势,而其瓶颈在于如何掌握每一个身体部位里存在的各种细胞类型。墨菲指着一条终有一日会植入老鼠体内的人造血管说:“我明天就可以帮你打印出一坨肝脏细胞,可是截至目前,我们在打印肝脏细胞时,还没办法同时在肝脏内部生成血管。”因为要是没有源源不绝的养分流入,位于中心的细胞就会死去。就目前的技术而言,要让血管系统里的细胞设置就绪并能够适应人类血压,必须耗费数天的时间。如果在完成前就先输送液体,微小的结构体就会爆裂开来。
墨菲说,现在的主要问题就是要克服技术障碍,让一个完整的人工部位里的各种细胞同时成熟。至于公司克服眼前困难的可能性有多大,墨菲表示:“唯一的阻碍就是投资。如果政府决定把这件事列为优先级,那么只需要几年时间,技术就能成熟。”
 来源:AI产业研究中心
来源:AI产业研究中心或许有一天,合成替代组织、奇迹疗法、长生不老的细胞系,会是解决全球人体组织短缺问题的关键所在;或许有一天,工业生产设施有可能会取代那些采集人体以求延命的人体交易市场。我们都想相信,匠心独运的科学企业家会提供替代方案来解决今日的问题。人们并没有很想要改变目前的状况,这是因为大家都认为今日的伦理难题在不久之后,就会像是遥远过去的时代错误。但是,与其活在不确定的未来,倒不如探究人体市场供应链里真正的状况。
《人体交易》
(美)斯科特·卡尼 著
姚怡平 译
上海译文出版社
2022年4月出版
内容简介
作者追踪人体交易5年,揭开了这一庞大而隐秘的经济系统:人体市场。
作者的此次全球人体市场之旅,揭露了这一产值高达数十亿美元的地下贸易在历史上的兴衰和复兴,并展现了早期的医疗研究和现代大学、赤贫的欧亚村落和高科技的西方实验室、盗尸人和代理孕母、人骨贩子和卖身体部位维生的穷人。
虽然地方上和国际上的执法人员均严格取缔人体交易,但是科学的进步造成了市场对人体组织的需求日益增长。令人在窥见种种不忍卒睹、荒诞离奇的现象之余,不由得思考其中的道德困境,以及这一鲜为人知的全球人体产业对当下和未来人类的生活所造成的影响。
作者简介
斯科特•卡尼(Scott Carney),美国调查记者兼人类学家,《连线》杂志特约编辑,报道常见于美国NPR(国家公共电台)、加拿大CBC(加拿大广播公司)、英国BBC及美国国家地理等频道,以及Mother Jones、Fast Company、Discover、Foreign Policy等杂志。
为进行新闻调查,他曾在世界上一些最危险、最不可能的角落工作,其作品融合了非虚构叙事和民族志。其间,为调查全球人体器官买卖内幕,他在印度等地居住、调查十年之久。2010年,他因其报道Meet the Parents获“佩恩新闻伦理奖”,该报道追踪了一个从国际绑架到收养的团伙的过程,在此报道的基础上他完成了《人体交易》的部分内容。他目前居住于美国丹佛。
原标题:《人体交易,长生不老的承诺?》
本文为澎湃号作者或机构在澎湃新闻上传并发布,仅代表该作者或机构观点,不代表澎湃新闻的观点或立场,澎湃新闻仅提供信息发布平台。申请澎湃号请用电脑访问http://renzheng.thepaper.cn。





- 报料热线: 021-962866
- 报料邮箱: news@thepaper.cn
互联网新闻信息服务许可证:31120170006
增值电信业务经营许可证:沪B2-2017116
© 2014-2026 上海东方报业有限公司




